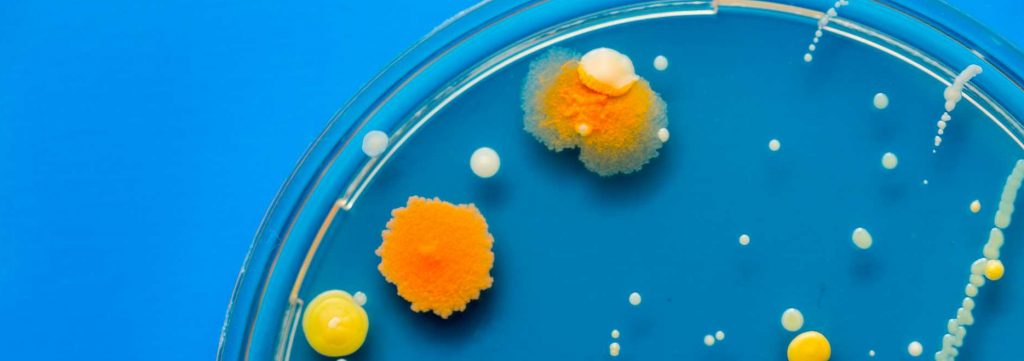
petri dish bacteria growth experiment

Antimicrobial Stewardship Draft
Antimicrobial Stewardship (AMS) is a systematic approach to optimising antimicrobial use, with a view to improving patient outcomes, minimising adverse events and decreasing the rate of antimicrobial resistance.
Each facility has a local AMS program. A suitable resource to inform antibiotic indication, dosing and length of treatment is the Therapeutic Guidelines. Refer to the following pages, pharmacy department or AMS pharmacist for further information:
- Caboolture Hospital (QHEPS)
- Redcliffe Hospital (QHEPS)
- Royal Brisbane and Women's Hospital (QHEPS)
- The Prince Charles Hospital (QHEPS)

